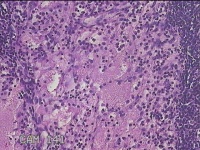

| 图片: | |
|---|---|
| 名称: | |
| 描述: | |
- 双侧鼻腔新生物
-
zzg19850715 离线
- 帖子:4332
- 粉蓝豆:5
- 经验:5895
- 注册时间:2017-10-14
- 加关注 | 发消息
| 性别 | 男 | 年龄 | 55岁 | 临床诊断 | 1.慢性鼻窦炎 2.鼻腔新生物 3.鼻中隔偏曲 4.过敏性鼻炎 |
|---|---|---|---|---|---|
| 一般病史 | 反复鼻塞、脓涕伴嗅觉减退20余年。 | ||||
| 标本名称 | 双侧鼻腔新生物 | ||||
| 大体所见 | 灰白粉红色肿物2.3x1.3x0.3cm两个,表面光滑,切开肿物呈囊性,囊内充满大量灰白色角化物,囊壁厚0.1cm。 | ||||
标签:
×参考诊断